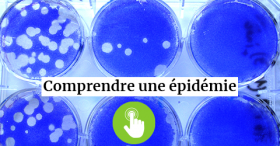

SARS-CoV-2 : quel est ce virus émergent ?
Un virus émergent

Le virus responsable de l’épidémie COVID-19 actuelle, est un virus de la famille des coronavirus, dénommé SARS-CoV-2, en raison du syndrome respiratoire aigu sévère (SRAS en français ou SARS en anglais) qu’il peut causer aux personnes qu’il infecte. Il ressemble au SARS-CoV responsable de la première épidémie de ce type survenue en Asie en 2002-2003. Un virus de la même famille a été à l’origine d’une épidémie (MERS, Middle-East Respiratory Syndrome en anglais) du même type au Moyen-Orient en 2012, ce dernier virus circule toujours de manière sporadique et n’est plus responsable d’epidémie.
D’où vient-il ?
Les premiers malades ont été détectés en Chine à la mi-décembre 2019, dans un hôpital de Wuhan une ville d’environ 14 millions d’habitants dans la province de Hubei, grande plate-forme commerciale avec un aéroport international. Le génome du virus à l’origine de cette maladie a été rapidement séquencé ce qui a mis en évidence sa forte ressemblance avec le coronavirus à l’origine de la première épidémie de SARS en 2002, un virus passé de la chauve-souris à l’homme via l’infection intermédiaire de civettes, des petits carnivores vendus sur les marchés en Chine. L’enquête pour comprendre l’origine de ce nouveau SARS, appelé dorénavant SARS-CoV-2, s’est donc orientée vers les marchés, zones de forte densité humaine et où sont vendus beaucoup d’animaux domestiques et sauvages, parmi lesquels chauve-souris, serpents et pangolins (petits mammifères).
SARS-Cov-2 nous vient du monde animal
Un virus, c’est un support d’information génétique (un ARN dans le cas du coronavirus) dans une enveloppe protéique. Les analyses génétiques des virus infectant les chauve-souris d’une part et les pangolins d’autre part laissent supposer aujourd’hui qu’il pourrait y avoir eu une recombinaison génétique entre un coronavirus de chauve-souris (96 % d’identité avec SARS-CoV-2) et un coronavirus de pangolin (91 % d’identité). Les virus, lorsqu’ils infectent un organisme pour s’y reproduire, ont en effet la capacité de muter ou de recombiner entre virus proches. A la faveur de ces changements génétiques, les virus peuvent acquérir la capacité d’infecter de nouveaux hôtes, par exemple ici l’humain. Le coronavirus à l’origine du SARS-Cov-2 nous vient donc du monde animal, il infectait les chauve-souris et il est probablement passé par un hôte animal intermédiaire comme le pangolin ou un autre animal pour créer un nouveau virus capable d’infecter l’homme.
Où s’installe-t-il dans le corps humain ?
Un virus a besoin d’entrer dans une cellule pour pouvoir se reproduire
Chez l’Homme, le SARS-CoV-2 se multiplie dans les cellules du système respiratoire.
Le virus est un parasite cellulaire obligatoire, c’est-à-dire qu’il a besoin d’entrer dans une cellule pour pouvoir se reproduire. Pour entrer dans une cellule, le coronavirus utilise des protéines de son enveloppe (pour SARS-CoV-2, il s'agit de la protéine « Spike » qui forme les motifs de sa couronne) pour reconnaitre une protéine particulière à la surface des cellules. Ces interactions sont spécifiques, comme une clé reconnaitrait une serrure. Plusieurs organes ont des cellules présentant les récepteurs nécessaires à SARS-CoV-2 : le nez, la gorge, les poumons, le coeur, l'intestin et les reins.
Génétique, l’âge, le statut immunitaire, d’autres maladies influencent la sensibilité d'un individu
De nombreux facteurs peuvent influencer la sensibilité d’un individu à un virus, comme la génétique, l’âge, le statut immunitaire, d’autres maladies. La sévérité des symptômes peut également être très différente selon les individus, de symptômes bénins de toux et de maux de gorge, à une pathologie sévère pouvant entrainer une pneumonie et des insuffisances respiratoires. Certaines personnes peuvent également présenter des symptômes digestifs (du type gastro-entérite) et parfois des pertes temporaires de goût et d’odorat.
A l’inverse, chez certains, l’infection peut également être complètement asymptomatique, ce sont des « porteurs sains ». Ceci explique qu’il ait été difficile d’identifier le « patient 0 » : le premier humain à avoir contracté la maladie. Pouvoir l'identifier rapidement aurait été utile pour permettre de contenir la progression de l'épidémie. On aurait ainsi pu veiller sur les personnes qu'il avait rencontrées afin de s'assurer qu'elles n'aient pas contracté le virus à son contact et prendre des précautions pour qu'elles ne diffusent pas, à leur tour, le virus. On ne connaît que la première personne malade, c’est-à-dire présentant des symptômes. Un patient 0 asymptomatique pourrait avoir été contaminé il y a plusieurs mois !
Comment se diffuse-t-il ? Sur quels supports peut-on le trouver ?
La transmission entre individus par de minuscules gouttelettes
Ces coronavirus sont des virus respiratoires, ils utilisent pour porte d’entrée nos voies aériennes (le nez et la bouche). Ils franchissent la barrière des muqueuses du nez, de l’œsophage puis des bronches pour atteindre les cellules où ils se reproduisent, mais aussi les muqueuses conjonctives de l’oeil. Leur transmission entre les individus se fait par des minuscules gouttelettes (d’une taille inférieure à quelques millièmes de mm) que nous émettons chaque fois que nous toussons, éternuons, mais aussi lorsque nous parlons. Une personne infectée dissémine ainsi des virus dans ces gouttelettes qui peuvent être inspirées par des personnes à proximité qui risquent alors à leur tour d’être contaminées. Cette dissémination peut également se faire par les mains dans le cas du COVID-19, en touchant par exemple des surfaces après avoir éternué, y déposant ainsi des virus qui pourront ensuite être transmis. Les virus responsables de nos rhumes ou de la grippe utilisent des modes de transmission similaires. Certains patients atteints par l"épidémie COVID-19 présentent des pathologies digestives et du génome viral est retrouvé dans les selles. Toutefois, la présence de génome viral n’implique pas que ce virus soit infectieux, et à ce jour la transmission par la voie fécale-orale n’a pas été mise en évidence.
Il est encore difficile d’estimer sa résistance réelle dans l’environnement
Selon la taille des gouttelettes émises, le virus peut persister plus ou moins longtemps dans l’air ambiant, il est toutefois difficile de connaitre précisément ce temps, car il dépend de l’environnement (fermé ou ouvert) et d’autres facteurs comme la température et l’humidité. De la même manière, la résistance du virus déposé sur des surfaces peut varier selon leur nature , comme le plastique, cuivre ou métal, sur lesquelles le virus peut conserver une infectiosité de quelques heures à quelques jours (selon une expertise de l'Anses). Toutefois toutes ces études ont été réalisées dans des conditions de laboratoires et il est encore difficile d’estimer la résistance réelle du virus dans l’environnement.
Qu’est-ce qui peut le détruire ?
Le coronavirus est, comme tous les virus, sensible aux UV et à la chaleur. La cuisson des aliments est notamment un bon moyen d’éliminer tout risque de contamination via des aliments manipulés par des personnes infectées (ce risque semble être toutefois faible).
Le savon, les détergents et les gels hydroalcooliques dégradent également l’enveloppe du virus, constituée de protéines et de lipides. C’est pourquoi ces gestes barrières sont efficaces et qu’il est important de les respecter.
Comment s’en protéger ?
Les masques sont utiles
Les masques sont utiles. Ils sont de deux types. Les masques utilisés par les soignants en milieu hospitalier (type FFP2) bloquent le virus (dont la taille est d’environ 200 nm) sans bloquer la respiration. Ce sont des masques de haute technologie et ils doivent être réservés aux soignants.
Les autres masques bloquent les postillons, les gouttelettes, etc. (qu’on émet ou qu’on reçoit), ils limitent donc la transmission de virus entre individus. Ces masques sont constitués de tissus ou de papiers très serrés…Il faut dans tous les cas éviter de se toucher le visage.
Les masques doivent être utilisés en plus des gestes barrières et du respect d’une distance de sécurité suffisante entre les personnes (de l'ordre de 1,5 mètre).
Les gants ne sont pas indispensables si on se lave régulièrement les mains (sauf pour le personnel soignant) et qu’on veille à ne pas se toucher le visage lors des courses par exemple.

Dans le contexte de la crise du Covid-19, le plastique revient en force en dépit de la loi du 1ᵉʳ janvier 2020 relative à l’interdiction de l’utilisation de certains objets plastique à usage unique (pailles, couverts…). Nathalie Gontard INRAE Occitanie - Montpellier et Valérie Guillard, université de Montpellier comparent notamment les masques plastique et les masques en fibres naturelles.
Pouvons-nous l’éliminer ?
Notre organisme, une fois infecté par un pathogène, se protège d’une réinfection en fabriquant différents types d’anticorps. Produits par les cellules immunitaires, ils permettent de reconnaître le pathogène et de l’éliminer. Un malade une fois guéri est immunisé contre le virus en produisant des anticorps spécifiques (IgG), ce qui l’empêchera de contracter l’infection une seconde fois. Toutefois, on ne connait pas encore l’efficacité de l’immunisation spécifique contre SARS-CoV-2, on ne sait pas combien de temps peut durer cette immunité.
Le virus peut-il contourner notre résistance ?
Le virus SARS-CoV-2 mute moins vite que le virus de la grippe par exemple. C’est en tout cas ce que semble montrer le suivi des génomes viraux réalisé au niveau mondial par le système de surveillance de la malaide COVID-19. Si des différences de séquences sont observées entre les virus circulants dans différents pays aujourd’hui, elles sont mineures et globalement on a toujours un même virus SARS-CoV-2 qui circule depuis le début de l’épidémie.
A plus long terme, de nouvelles souches de SARS-CoV-2 pourraient émerger et revenir de manière sporadique (dans une région donnée) ou cyclique (comme la grippe saisonnière).
Pourrait-il se combiner avec d’autres virus, tels que celui de la grippe par exemple ? C’est peu probable, il s’agit de virus ayant des structures et des génomes très différents, les virus grippaux appartiennent à la famille des influenza contraitement à SARS-CoV-2 qui est un coronavirus. Or les réarrangements sont observés entre virus de même familles.
Le saviez-vous ? Les virus ont trois façons d'évoluer : 1/ par mutations de leur acide nucléique (ADN ou ARN) qui peuvent survenir à chaque cycle de reproduction 2/ par recombinaison des acides nucléiques entre deux virus de la même famille qui se reproduisent dans la même cellule 3/ par réassortiment : cela ne concerne que les virus pourvus de plusieurs morceaux d'acide nucléique, comme les virus grippaux. Au cours du cycle de reproduction, des morceaux différents peuvent être associés et former une nouvelle variante du virus.
Les tests de détection
Comment peut-on savoir si on est infecté ?
Les test de détection du virus sont basés sur la technique de PCR ( pour Polymerase Chain Reaction). Ce sont des tests moléculaires qui repèrent la présence du génome du virus et peuvent en mesurer la quantité chez un individu. Les premiers tests de ce type ont été développés en Chine puis standardisés par l’OMS et développés dans tous les pays. Ce type de test est le plus indiqué pour détecter et suivre la progression de la maladie chez les patients. Ces tests PCR utilisent des échantillons de cellules prélevées dans le nez avec des écouvillons. Les résultats sont disponibles en quelques heures/jours (3-4 heures en milieu hospitalier, 3 à 5 jours sinon). Ces tests sont très spécifiques, en revanche il peut y avoir des « faux négatifs » : c’est-à-dire des personnes infectées chez qui le test ne décèle pas le virus. Cela est dû à des mauvais prélèvements et/ou une charge virale faible au moment du prélèvement (trop tot ou trop tard).
Comment peut-on savoir si on a été infecté ?
Ces tests (dits sérologiques) sont réalisés à partir de prélèvements sanguins. Ils identifient les anticorps produits par les cellules immunitaires d’un organisme une fois que celles-ci ont été en contact avec le virus. Ces anticorps sont alors retrouvés dans la circulation sanguine. Les tests analysent les anticorps non spécifiques (IgM) et spécifiques anti-SARS-CoV-2 (IgG)
Rappelons-nous, ce sont les anticorps qui assurent notre défense contre les virus.
Pour ce type de test, seule une prise de sang suffit et le résultat est très rapide.
Des tests essentiels au suivi de l'épidémie

Les tests sérologiques permettent d’évaluer l’immunité globale de la population : combien de personnes ont déjà été exposées au virus et sont devenues « résistantes » (toutefois le niveau d’immunité des personnes non/peu symptomatique n’est pas connu à ce jour). C’est ce que l’on appelle l’immunité de groupe. Connaissant le taux de transmission du SARS-CoV-2 (une personne infectée contamine en moyenne entre 3 et 5 personnes), il est estimé qu’il faut que 70 % de la population environ soit immunisée pour que l'ensemble de la population soit protégée, y compris les personnes qui ne sont pas immunisées (les plus fragiles). Atteindre ce niveau d’immunité "globale" de manière naturelle ou vaccinale permettrait un retour « à la vie normale » et sonnerait la fin de la circulation du virus. Toutefois, de nombreuses études dans différents pays du monde y compris en France montrent que nous n'avons pas atteint ce niveau de protection. Dans l’attente de solutions thérapeutiques ou vaccinales, au moment du déconfinement, la voie est de limiter au maximum la circulation du virus pour protéger l’ensemble de la population et notamment les personnes les plus fragiles. Ceci pourra être réalisé en testant (par PCR) les personnes qui ont des symptômes évocateurs du COVID-19 et envisager le confinement des personnes positives au test, donc porteuses du virus.
Quels traitements ?
Seuls les vaccins et les médicaments antiviraux sont efficaces contre des virus
Les médicaments antiviraux en test aujourd’hui sont des molécules ayant déjà montré une efficacité contre d’autres virus. Ils ciblent les mécanismes d’entrée du virus dans la cellule ou sa réplication (la machine qui lui permet de se reproduire). La réplication virale peut impliquer des mécanismes similaires entre virus différents, on teste des molécules qui ont déjà montré une efficacité contre HIV ou Ebola (ex Lopanovir/Ritonavir, Remdesivir). De la même manière, l’entrée d’un virus dans une cellule peut impliquer des mécanismes similaires pour différents virus voire microorganismes. Des molécules bloquant ces étapes précoces de l’infection sont aussi en test (Hydroxychloroquine, Ivermectine voire tout récemment la nicotine). Dans tous les cas, il est nécessaire d’avoir une connaissance fine du SARSCoV-2 pour mettre au point rapidement des médicaments. Actuellement de nombreux tests de molécules antivirales sont réalisés dans le monde afin de déterminer leur efficacité. C’est le cas en Europe du programme Discovery piloté par l’Inserm qui concerne plus de 800 patients en France.
Les antibiotiques s’attaquent aux bactéries et non aux virus. Ils sont toutefois utilisés en cas de complications respiratoires dues à des sur-infections bactériennes qui aggravent la pathologies.
Les vaccins, traitement préventif les plus indiqués pour les maladies virales, permettent d’acquérir l’immunité contre le virus sans avoir été attaqué. Sur le même principe que décrit ci-dessus, si 70% de la population est vaccinée (immunisée), les personnes fragiles qui ne peuvent pas être vaccinées ou chez lesquelles la vaccination est moins efficace (notamment les personnes agées) sont mécaniquement protégées par l’immunité du groupe. Toutefois la mise au point de vaccin demande 18 mois à 2ans, de la mise au point de la stratégie vaccinale à la mise en production à grande échelle.
EDITORIAL
Rédaction de la page : Nicole Ladet, Charlotte Mermier, INRAE
Podcast : Charlotte Mermier, INRAE
Infographie : Véronique Gavalda, INRAE
SCIENTIFIQUE
Mylène Ogliastro
UMR DIGMI Diversité, génomes & interactions Microorganismes–Insectes, INRAE - Université de Montpellier
Centre INRAE : Occitanie-Montpellier
Départements scientifiques INRAE : Santé animale, Santé des plantes